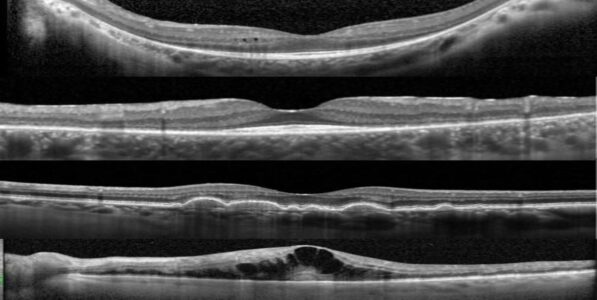

À Retenir
L’OCT est une technique d’imagerie rétinienne essentielle pour le diagnostic et le suivi des maladies oculaires. Cet examen non invasif fournira des informations cruciales sur la santé de votre rétine et votre nerf optique. Il est souvent le premier examen réalisé en cas de baisse d’acuité visuelle ou d’atteinte du champ visuel.
Qu'est-ce que l'OCT (Tomographie par Cohérence Optique) ?
L’OCT (Tomographie par Cohérence Optique) est une technique d’imagerie non invasive et très précise qui permet d’obtenir des images en coupe transversale des différentes couches de la rétine. Elle est essentielle pour diagnostiquer, surveiller et traiter les maladies de la macula et du nerf optique.
Pourquoi cet examen est-il nécessaire ?
L’OCT est un outil diagnostic crucial pour plusieurs raisons :
- Diagnostic précoce des anomalies rétiniennes qui ne seraient pas visibles lors d’un examen standard du fond d’œil.
- Suivi des pathologies et adaptation de la prise en charge, pour les maladies chroniques telles que la dégénérescence maculaire liée à l’âge (DMLA), la rétinopathie diabétique, le glaucome, ou la myopie forte,
- Évaluation des couches rétiniennes : Elle offre une visualisation détaillée des différentes couches de la rétine, permettant de repérer des anomalies sur chacune d’entre elles de façon spécifique.
Comment se déroule un examen d'OCT ?
L’examen OCT est rapide, indolore et non invasif. Voici comment il se déroule :
- Préparation à l’examen :
- Dans certains cas, des gouttes de dilatation peuvent être utilisées pour améliorer la qualité des images obtenues. Dans ce cas, pour éviter l’éblouissement pendant quelques heures, pensez à apporter vos lunettes de soleil.
- Acquisition des images :
- Nécessité de fixer une lumière ou un point spécifique à l’intérieur de l’appareil et de limiter les clignements.
- Les scans prennent généralement quelques secondes à quelques minutes par œil.
- Analyse des résultats :
- Immédiatement disponibles pour l’ophtalmologiste, qui pourra ainsi décider de la suite de la prise en charge et réaliser un compte rendu de l’examen.
- Permet la confirmation diagnostic de la pathologie maculaire ou du nerf optique.
N’hésitez pas à discuter des résultats avec votre ophtalmologiste ICI pour comprendre les implications et le plan de traitement qui en découle.
Images en OCT de la région maculaire, objectivant des atteintes des
différentes couches de la rétine : kystes des couches internes de la rétine,
amincissement péri-maculaire des couches externes dans le cadre d’une
maculopathie à l’hydroxychloroquine, drusen, œdème maculaire.
Exemple d’un OCT maculaire et papillaire normaux.